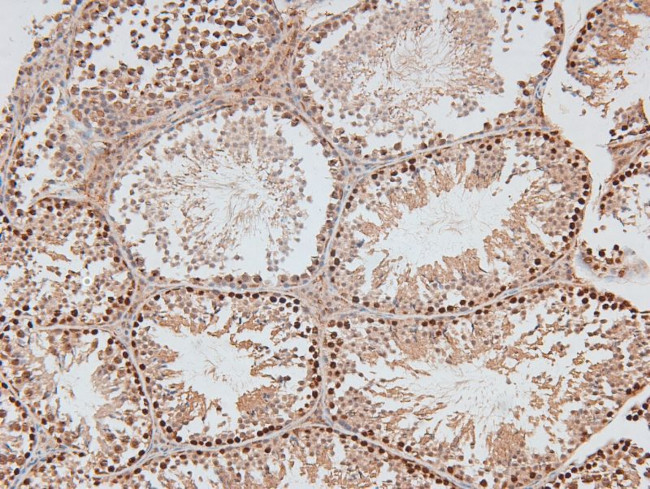
Phospho-DNA-PK (Thr2609) Antibody in Immunohistochemistry (Paraffin) (IHC (P))

Search
Invitrogen
Phospho-DNA-PK (Thr2609) Polyclonal Antibody
{{$productOrderCtrl.translations['antibody.pdp.commerceCard.promotion.promotions']}}
{{$productOrderCtrl.translations['antibody.pdp.commerceCard.promotion.viewpromo']}}
{{$productOrderCtrl.translations['antibody.pdp.commerceCard.promotion.promocode']}}: {{promo.promoCode}} {{promo.promoTitle}} {{promo.promoDescription}}. {{$productOrderCtrl.translations['antibody.pdp.commerceCard.promotion.learnmore']}}
图: 1 / 4
Phospho-DNA-PK (Thr2609) Antibody (PA5-105749) in IHC (P)




Please note: We are reviewing Western blot images included in the antibody testing data in our catalog, including those provided by third parties. Unless expressly labeled or annotated as “raw-unedited”, Western blot images included in the antibody testing data in our catalog may have been edited, optimized or otherwise adjusted for presentation.
产品信息
PA5-105749
种属反应
已发表种属
宿主/亚型
分类
类型
抗原
偶联物
形式
浓度
规格
纯化类型
保存液
内含物
保存条件
运输条件
RRID
产品详细信息
Antibody detects endogenous levels of DNA-PK only when phosphorylated at Thr2609.
靶标信息
DNA-PK is a heterotrimeric, DNA-dependent protein kinase that initiates signaling cascades in response to DNA damage. DNA-PK is an atypical kinase, closely related to the PI3 kinases, and is often potently inhibited by small molecules designed to target PI3 kinases. DNA-PK encodes a component of the mediator complex, a transcriptional coactivator complex thought to be required for the expression of almost all genes. The mediator complex is recruited by transcriptional activators or nuclear receptors to induce gene expression, possibly by interacting with RNA polymerase II and promoting the formation of a transcriptional pre-initiation complex. Multiple transcript variants encoding different isoforms have been found for DNA-PK.
仅用于科研。不用于诊断过程。未经明确授权不得转售。
生物信息学
蛋白别名: DNA-dependent protein kinase catalytic subunit; DNA-PK catalytic subunit; DNPK1; doxorubicin nephropathy; p460; S473K; Ser-473 kinase; severe combined immunodeficiency
基因别名: AI326420; AU019811; DNA-PKcs; DNAPDcs; DNAPK; DNPK1; DOXNPH; dxnph; HYRC; HYRC1; p460; PRKDC; scid; slip; XRCC7
UniProt ID: (Mouse) P97313
Entrez Gene ID: (Mouse) 19090, (Rat) 360748